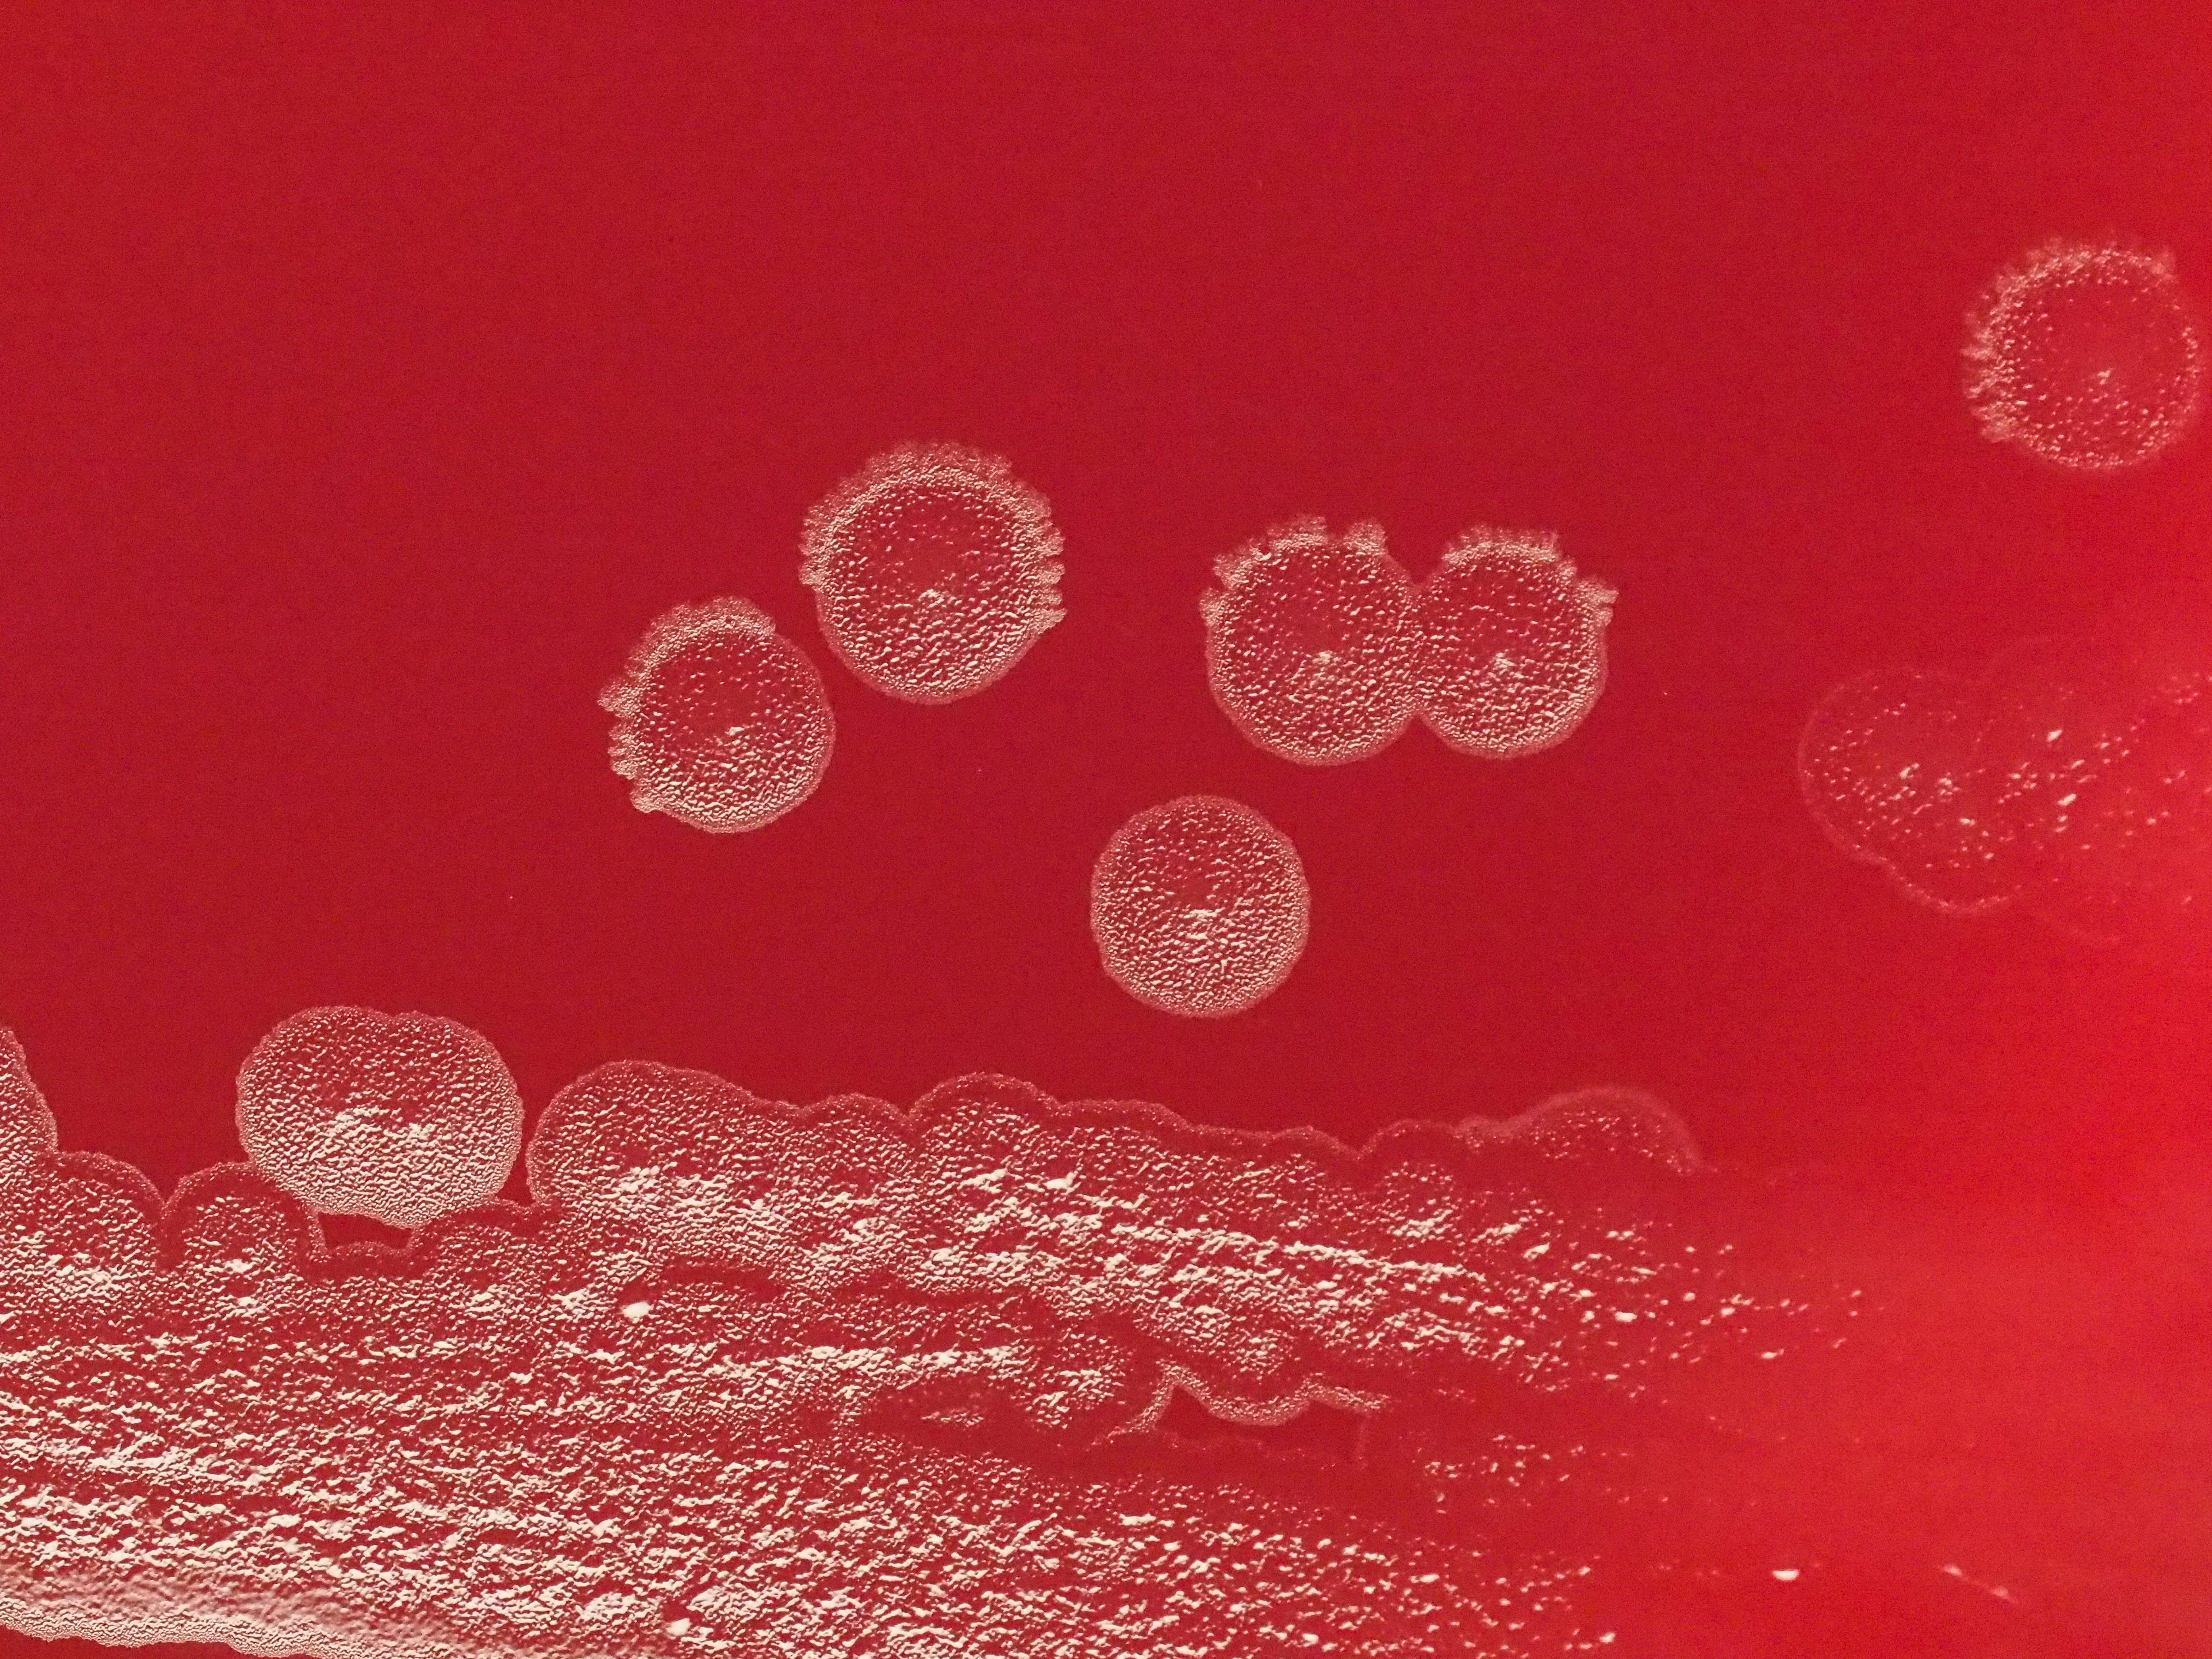

Archive
Insulin ResistanceInsulin Resistance
+1+1

Women's HealthWomen's Health
+1+1

Insulin ResistanceInsulin Resistance
+1+1

FertilityFertility
PCOSPCOS

FertilityFertility

PCOSPCOS

FertilityFertility

Insulin ResistanceInsulin Resistance
+1+1

Top 10 Foods That Trigger Insulin Resistance in PCOS
Many women with PCOS try to eat “healthy” but still feel exhausted, crave sugar, and struggle to regulate their cycles. This post uncovers the hidden foods that secretly spike insulin and worsen PCOS symptoms and shows you what to eat instead to finally support balanced hormones, stable energy, and better fertility.

Mariah Wilson


